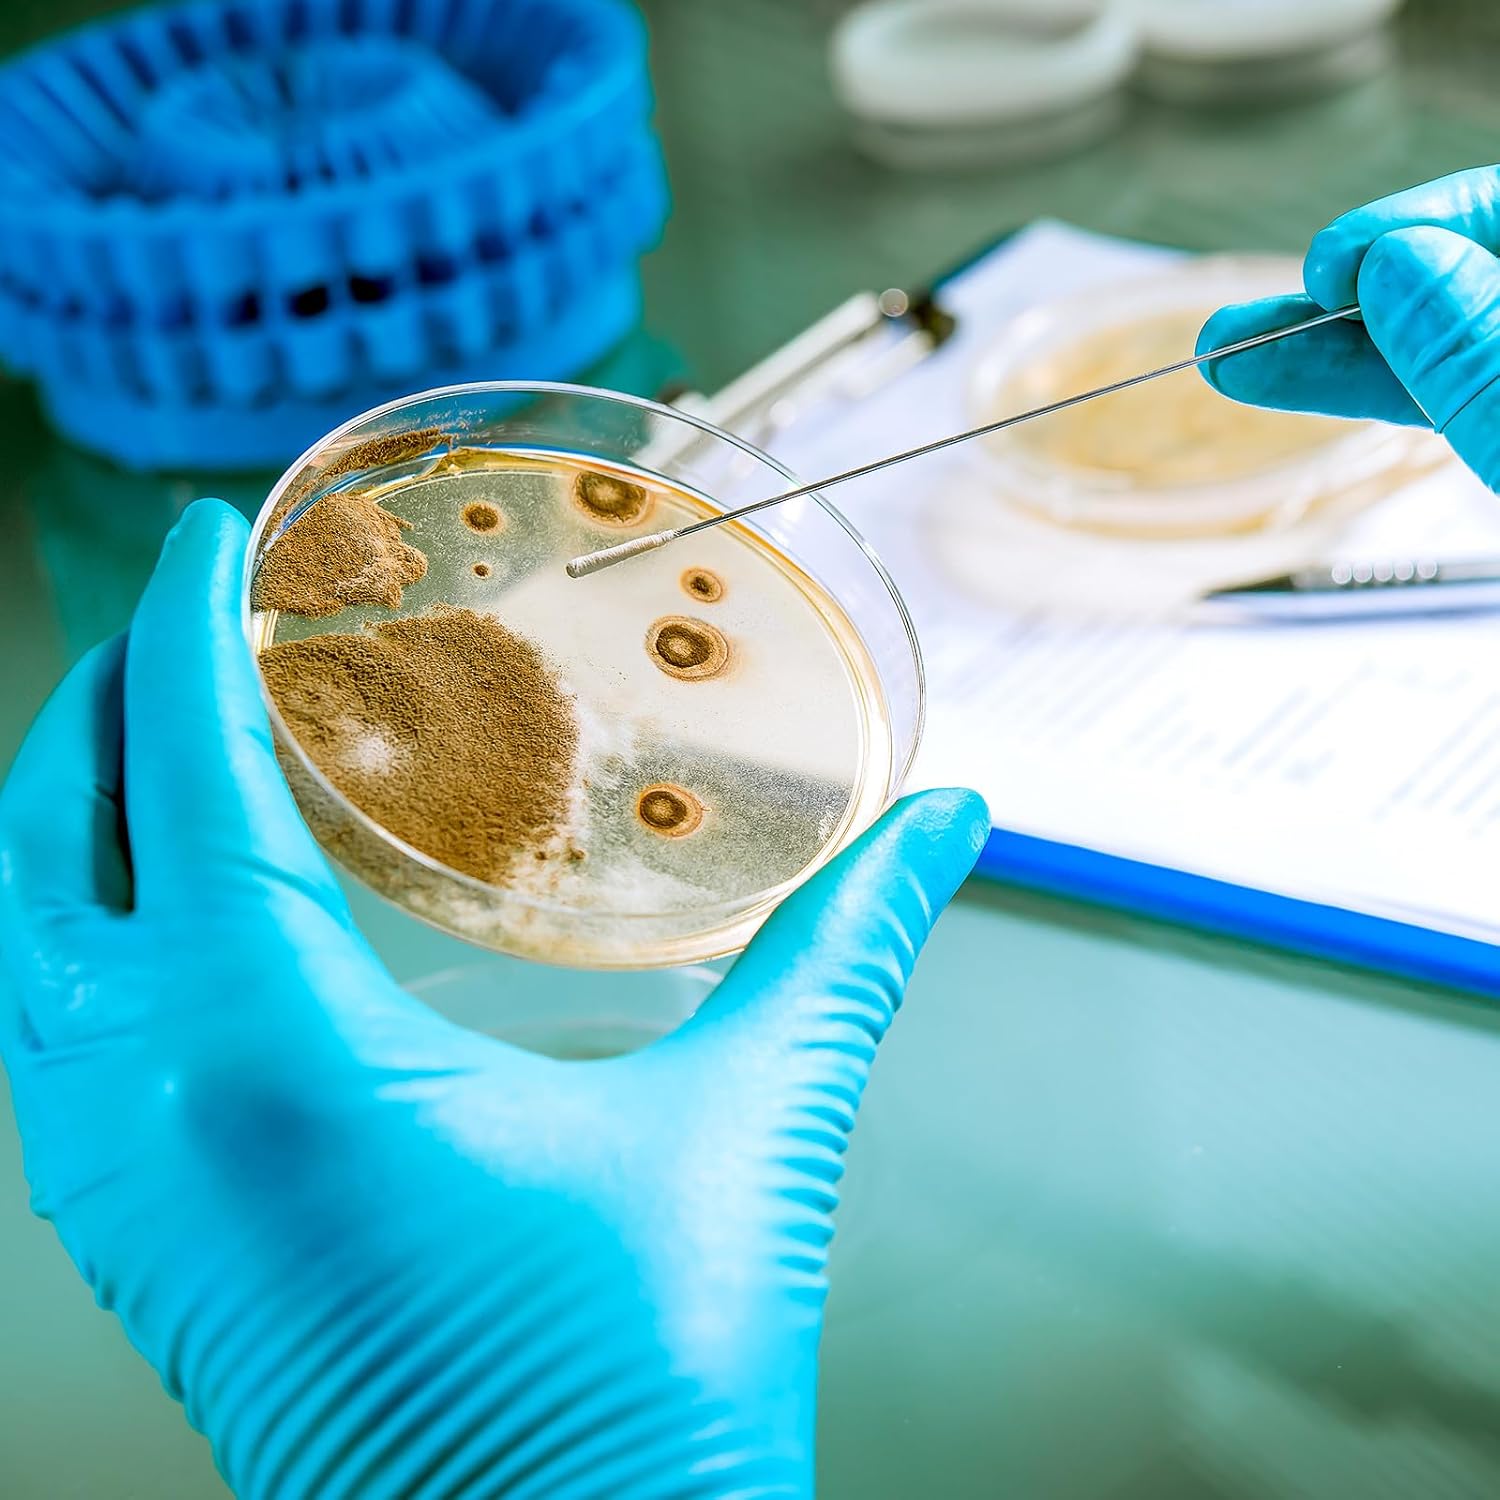

Información sobre el producto "BIMdepot | Kit de análisis de superficies AGAR muestras de contacto hisopos"
Kit BIMdepot de muestreo por contacto e hisopos para análisis de superficies profesionales: Incluye 5 placas de agar redondas en placas Petri y 5 hisopos para muestreo de superficies – ideal para filtros de aire, bandejas de condensados, paredes interiores, componentes de aire, áreas alimentarias o equipos de refrigeración. El análisis de muestras y la elaboración de informes (por ejemplo, según VDI 6022, HACCP o GMP) no están incluidos y son responsabilidad del usuario. Los hisopos se recomiendan para superficies de difícil acceso o irregulares.
Nota: Para más de 5 muestras se requieren kits adicionales.
Análisis microbiano y bacteriano
En agar TTC, la mayoría de las bacterias crecen como colonias rojas – también pueden aparecer hongos y levaduras. Las colonias incoloras también se incluyen en la evaluación. El factor decisivo son las Unidades Formadoras de Colonias (UFC), no el tamaño de la colonia. En alta carga microbiana, la superficie puede aparecer uniformemente coloreada o incolora debido al crecimiento intenso. La comparación con un medio fresco ayuda a evitar interpretaciones erróneas.
Valores de referencia:
- < 10⁴ UFC/ml = baja contaminación
- 10⁴ – 10⁶ UFC/ml = contaminación moderada
- > 10⁶ UFC/ml = alta, contaminación no aceptable
Notas importantes
- Este kit no incluye EPI, toma de muestras in situ ni servicios.
- El transporte, asesoramiento, planificación de medidas e interpretación se reservan por separado.
- Las estancias coordinadas o prolongadas requieren reserva independiente.
Asegurar cadenas de suministro de forma profesional
Para soporte completo de proceso y muestreo se recomienda la contratación de un BIM Facility Manager o inspector de higiene VDI (lun–jue, 4 días/semana).
Nota: El equipo de trabajo y los gastos de viaje no están incluidos – ver BIMconnect, BIMpilot o BIMservice.

0 de 0 valoraciones
Calificación promedio de 0 de 5 estrellas
Iniciar sesión
Otros también lo pidieron




